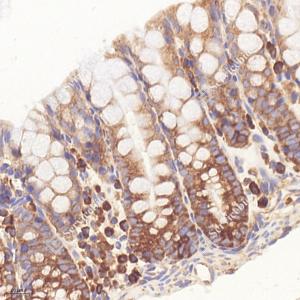
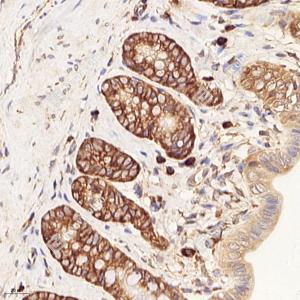

Anti-RPL10 Rabbit pAb
- 50 μL
产品信息
|
蛋白质全称 |
60S核糖体蛋白L10 |
|
别名 |
Protein QM homolog, Ribosomal protein L10, Rpl10, Qm, DXS648, L10, NOV, Tumor suppressor QM, Wilms tumor related protein, Protein QM, Laminin receptor homolog |
|
Uniprot ID |
Q6ZWV3 |
|
免疫原 |
KLH偶联的小鼠RPL10合成肽 |
|
抗体亚型 |
IgG |
|
预测分子量./观测分子量. |
25 kDa / 25 kDa |
|
纯化方式 |
亲和纯化 |
|
亚细胞定位 |
细胞核, 细胞质 |
应用
| 应用 | 物种 | 稀释 | 阳性样品 |
| WB 免疫印迹 | 人, 小鼠, 大鼠 | 1: 2000-1: 4000 | 胰腺 |
| IHC/IF 免疫组织化学/免疫荧光 | 人, 小鼠, 大鼠 | 1: 2000-1: 4000 | 扁桃体, 脑, 肾 |
| ICC/IF 免疫细胞化学/免疫荧光 | 人, 小鼠, 大鼠 | 1: 100-1: 400 | HeLa细胞, NIH 3T3细胞 |
背景
This gene encodes a ribosomal protein that is a component of the 60S ribosome subunit. The related protein in chicken can bind to c-Jun and can repress c-Jun-mediated transcriptional activation. Some studies have detected an association between variation in this gene and autism spectrum disorders, though others do not detect this relationship. There are multiple pseudogenes of this gene dispersed throughout the genome. Alternative splicing results in multiple transcript variants.
图像
|
|
WB检测RPL10蛋白(货号 GB113267). 样品: 经RIPA裂解液(货号G2002)处理的蛋白质. 封闭: 3%脱脂牛奶(货号GC310001)溶于TBST溶液, 室温孵育1小时. —抗: 1: 4000稀释, 4℃ 孵育过夜. 二抗: HRP标记山羊抗兔IgG (H+L) (货号GB23303), 1: 5000稀释, 室温孵育1小时. |
|
|
WB检测RPL10蛋白(货号 GB113267). 样品: 经RIPA裂解液(货号G2002)处理的蛋白质. 封闭: 3%脱脂牛奶(货号GC310001)溶于TBST溶液, 室温孵育1小时. —抗: 1: 4000稀释, 4℃ 孵育过夜. 二抗: HRP标记山羊抗兔IgG (H+L) (货号GB23303), 1: 5000稀释, 室温孵育1小时. |
|
|
WB检测RPL10蛋白(货号 GB113267). 样品: 经RIPA裂解液(货号G2002)处理的蛋白质. 封闭: 3%脱脂牛奶(货号GC310001)溶于TBST溶液, 室温孵育1小时. —抗: 1: 4000稀释, 4℃ 孵育过夜. 二抗: HRP标记山羊抗兔IgG (H+L) (货号GB23303), 1: 5000稀释, 室温孵育1小时. |
|
|
WB检测RPL10蛋白(货号 GB113267). 样品: 经RIPA裂解液(货号G2002)处理的蛋白质. 封闭: 3%脱脂牛奶(货号GC310001)溶于TBST溶液, 室温孵育1小时. —抗: 1: 4000稀释, 4℃ 孵育过夜. 二抗: HRP标记山羊抗兔IgG (H+L) (货号GB23303), 1: 5000稀释, 室温孵育1小时. |
|
|
IHC检测RPL10蛋白(货号 GB113267). 样品: 人扁桃体, 4%多聚甲醛 (货号G1101) 固定12-24小时. 抗原修复: 柠檬酸抗原修复液(干粉, pH 6.0) (G1201), 98℃, 20分钟. —抗: 1: 2000稀释, 4℃ 孵育过夜. 二抗: HRP标记山羊抗兔IgG (H+L) (货号GB23303), 1: 200稀释, 室温孵育1小时. |
|
|
IHC检测RPL10蛋白(货号 GB113267). 样品: 小鼠脑, 4%多聚甲醛 (货号G1101) 固定12-24小时. 抗原修复: 柠檬酸抗原修复液(干粉, pH 6.0) (G1201), 98℃, 20分钟. —抗: 1: 1200稀释, 4℃ 孵育过夜. 二抗: HRP标记山羊抗兔IgG (H+L) (货号GB23303), 1: 200稀释, 室温孵育1小时. |
|
|
IHC检测RPL10蛋白(货号 GB113267). 样品: 大鼠脑, 4%多聚甲醛 (货号G1101) 固定12-24小时. 抗原修复: 柠檬酸抗原修复液(干粉, pH 6.0) (G1201), 98℃, 20分钟. —抗: 1: 1200稀释, 4℃ 孵育过夜. 二抗: HRP标记山羊抗兔IgG (H+L) (货号GB23303), 1: 200稀释, 室温孵育1小时. |
|
|
IHC检测RPL10蛋白(货号 GB113267). 样品: 小鼠肾, 4%多聚甲醛 (货号G1101) 固定12-24小时. 抗原修复: 柠檬酸抗原修复液(干粉, pH 6.0) (G1201), 98℃, 20分钟. —抗: 1: 1200稀释, 4℃ 孵育过夜. 二抗: HRP标记山羊抗兔IgG (H+L) (货号GB23303), 1: 200稀释, 室温孵育1小时. |
|
|
IHC检测RPL10蛋白(货号 GB113267). 样品: 小鼠胰腺, 4%多聚甲醛 (货号G1101) 固定12-24小时. 抗原修复: 柠檬酸抗原修复液(干粉, pH 6.0) (G1201), 98℃, 20分钟. —抗: 1: 1200稀释, 4℃ 孵育过夜. 二抗: HRP标记山羊抗兔IgG (H+L) (货号GB23303), 1: 200稀释, 室温孵育1小时. |
|
|
IHC检测RPL10蛋白(货号 GB113267). 样品: 小鼠直肠, 4%多聚甲醛 (货号G1101) 固定12-24小时. 抗原修复: 柠檬酸抗原修复液(干粉, pH 6.0) (G1201), 98℃, 20分钟. —抗: 1: 1200稀释, 4℃ 孵育过夜. 二抗: HRP标记山羊抗兔IgG (H+L) (货号GB23303), 1: 200稀释, 室温孵育1小时. |
|
|
IHC检测RPL10蛋白(货号 GB113267). 样品: 大鼠直肠, 4%多聚甲醛 (货号G1101) 固定12-24小时. 抗原修复: 柠檬酸抗原修复液(干粉, pH 6.0) (G1201), 98℃, 20分钟. —抗: 1: 1200稀释, 4℃ 孵育过夜. 二抗: HRP标记山羊抗兔IgG (H+L) (货号GB23303), 1: 200稀释, 室温孵育1小时. |
|
|
ICC检测RPL10蛋白(货号 GB113267)(红色). 样品: HeLa细胞, 4%多聚甲醛 (货号G1101) 固定20分钟. 封闭: 3% BSA(货号GC305010)的PBS溶液, 室温孵育30分钟. 一抗: 1: 100稀释, 4℃ 孵育过夜. 二抗: Cy3标记山羊抗兔IgG (H+L) (货号GB21303), 1: 300稀释, 室温孵育1小时. |
|
|
ICC检测RPL10蛋白(货号 GB113267)(红色). 样品: NIH-3T3细胞, 4%多聚甲醛 (货号G1101) 固定20分钟. 封闭: 3% BSA(货号GC305010)的PBS溶液, 室温孵育30分钟. 一抗: 1: 100稀释, 4℃ 孵育过夜. 二抗: Cy3标记山羊抗兔IgG (H+L) (货号GB21303), 1: 300稀释, 室温孵育1小时. |
储存
| 储存条件 | 在-20℃下储存一年, 避免反复冻融. |
| 储存缓冲液 | 含0.15% ProClin300防腐剂, 100 μg/mL牛血清白蛋白和50%甘油的磷酸盐缓冲液. |
注意:
1.本产品仅供研究使用.
2.建议用一抗稀释液(G2025)稀释本产品.
| 货号 | 名称 | 规格 | 价格 | 操作 |
|---|
| 货号 | 名称 | 规格 | 价格 | 操作 |
|---|